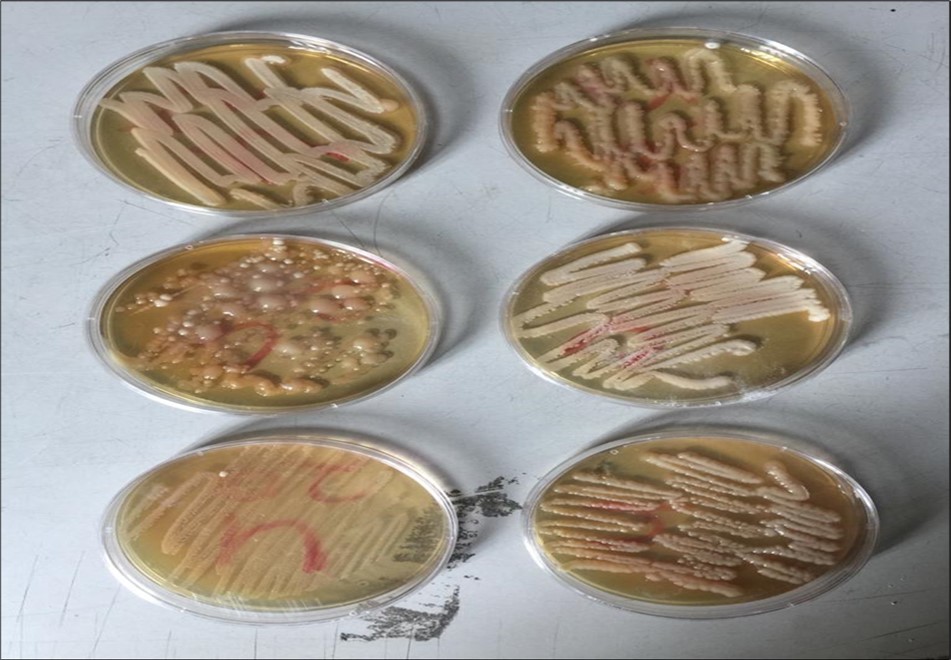
Plates showing Culture Positive Cases

Prevalence and Antifungal Susceptibility of Candida species from patients attending Rivers State University Teaching Hospital, Nigeria
Abstract
The development of medical therapy and patients profile has led to a rise in the incidence of nosocomial fungal infection. The frequency of candidiasis has surged worldwide, and the prevalent of healthcare diseases are now Candida species. Candida species causes a range of human infections known as Candidiasis. The non-albicans Candida (NAC) species have recently superseded Candida albicans as significant opportunistic pathogens. The study was conducted to determine the prevalence and antifungal susceptibility of Candida species isolated from various Clinical samples in Rivers State University Teaching Hospital, Port Harcourt, Nigeria. A total of 206 clinical specimens from male and female patients of all ages were sampled in the Department of Microbiology, Rivers State University Teaching Hospital, Port Harcourt, to investigate suspected Candida infections. The isolation and identification of Candida species was done by culture on SDA, Gram stain, sugar fermentation and phylogenetic profiling. Antifungal susceptibility pattern was done by Disc Diffusion method using Fluconazole, Ketoconazole, Miconazole, Nystatin and Itraconazole. The results showed that out of 206 specimens, 44 isolates (21.4%) were identified, with the majority (56.82%) from high vaginal swabs (HVS), followed by urine (31.82%) and oral swabs (11.36%). The age of patients ranged from four months to 73 years giving a Mean Age 1.86+ 0.344, with females (85.4%) outnumbering males (13.6%). Prevalence of Candida spp revealed Candida albicans (50%), Candida krusei (18.2%), Candida parapsilosis(11.4%), Candida glabrata and Candida tropicalis (9.1%) respectively and Candida pelliculosa (2.2%), with C. albicans being the most prevalent. The antifungal susceptibility testing among the azoles showed that Fluconazole (79.5%) and Ketoconazole (77.3%) were most sensitive agents against isolates from HVS, urine and oral swabs respectively and Itraconazole (34.1%) was most resistant especially to those from oral swabs. This study highlights the increasing prevalence of NAC species over Candida albicans and the growing resistance of Candida isolates to commonly used antifungal drugs. Diagnosis of these species of Candida and sensitivity to antifungal agents are critical components to treatment, particularly for patients with severe underlying illnesses who are hospitalized.
Author Contributions
Copyright © 2024 Girah. D. N, et al
This is an open-access article distributed under the terms of the Creative Commons Attribution License, which permits unrestricted use, distribution, and reproduction in any medium, provided the original author and source are credited.
Competing interests
The authors declare that there was no conflict of interest.
Citation:
Introduction
In a worldwide scale, Candida species are the most common cause of fungal infections in humans. There are around 200 species in the Candida genus, with over 20 known to be significant agents of hospital-acquired infections, contributing to about 8-10% of all nosocomial infections 1. Candida species are responsible for a wide range of human infections known as candidiasis, including superficial ones like oral thrush and vulvovaginal candidiasis, as well as more severe infections such as candidemia and stomatitis which are said to be ventures 2. They can be found in various parts of the body like the mouth, throat, intestines, and genital and urinary tracts, making them one of the most common fungal pathogens causing diseases in humans 3, 4. Candida infections can manifest in various chronic forms, with Candida albicans being the main culprit behind most superficial and systemic Candida infections as documented by 5. The majority of Candida infections according to 6 affect the body's epithelial surfaces. Gastrointestinal candidiasis has been identified as a common cause of peptic ulcers, as Candida yeasts naturally inhabit the mouth and can lead to gastroesophageal inflammation, affecting up to 88% of patients. Candida yeast infections in the cardiovascular system are rare, except when they are in specific materials like blood, cerebrospinal fluid, or specialized culture media 6.
Candidiasis is considered one of the most widespread opportunistic fungal infections affecting humans globally. The organism mainly responsible for these infections is C. albicans, which naturally resides in the human intestinal system 1. C. albicans accounts for approximately 70% of all Candida infections in humans with the remaining 30% caused by non-albicans Candida (NAC) species such as C. tropicalis, C. glabrata, C. parapsilosis, and C. krusei. These non-albicans Candida species are frequently identified in various sources like soil, animals, hospitals, and foods, and their prevalence has been noted 7, 3. It is estimated that more than 30% of the global population, mostly women over the age of twelve, are affected by Candida infections 8. Candida albicans plays a significant role in systemic candidiasis (45.3%), organ dysfunction, and mortality linked to the use of polyene antifungals as stated by 9.
The increase in predisposing conditions such as age, poor oral hygiene, HIV/AIDS, malnutrition, smoking, immune suppression, endocrine-related diseases, and changes in the epithelial cells have led to the rise in Candida infections 4. Hospitalized patients worldwide are frequently affected by healthcare-associated infections, which significantly contribute to morbidity and mortality. Fungal nosocomial infections, especially candidemia, have been described as epidemic and a major factor the morbidity and mortality of critically ill patients 10. Research by 11, has shown a decrease in the prevalence of Candida albicans as the causative agent of candidiasis, with a simultaneous increase in non-albicans Candida (NAC) species due to the extensive use of antifungal medications for longer treatment durations. Various classes of antifungals, including azoles, polyenes and echinodins like Fluconazole, have been used in the treatment of Candida infections. Additionally, Amphotericin B and Nystatin have become preferred medications for treating superficial fungal infections caused by Candida species 12, 4. Antifungal susceptibility testing is crucial for selecting the most effective antifungal treatment for a specific fungal infection by detecting antifungal resistance. This testing is essential for optimizing treatment and improving patient outcomes, making it a valuable tool in medical mycology 13.
The incidence of candidiasis has been on the rise in recent years due to various risk factors like prolonged catheterization, extensive surgical procedures, use of immune-suppressive medications, HIV infections, and other conditions affecting immunocompromised individuals. The increase in candidemia poses a severe threat , particularly to critically ill patients. The emergence of non-albicans Candida species as both colonizers and pathogens causing nosocomial fungal bloodstream infections has complicated the overall rise in candidemia. Different Candida species, such as C. albicans and C. krusei have been identified globally with varying antifungal susceptibility profiles. Though antifungal medications are available, Candida remains a significant medical challenge, exacerbated by the emergence of non-albicans Candida species and their resistance to existing antifungal drugs, making treatment increasingly difficult. Since the treatment of candidiasis if often empiric, selecting antifungal agents should be based on the likelihood of the pathogen and their resistance pattern anticipated in a specific region. Therefore, regular surveillance of causative agents of candidiasis and their resistance patterns in a given locality is crucial. In Rivers State, there is inadequate research on the resistance patterns of Candida species causing candidiasis in different clinical samples. No data has been published regarding yeast resistance in Otomycosis, Candiduria and Vulvovaginal candidiasis at the Rivers State University Teaching Hospital in Port Harcourt city Rivers State metropolitan area. This study aims to investigate the prevalence patterns and antifungal susceptibility among patients at the facility.
Materials and Methods
This research was conducted as a cross-sectional observational study in the Department of Microbiology Rivers State University Teaching Hospital (RUSTH) Port Harcourt, Nigeria. It is a State Government-owned Teaching Care Hospital. The study was carried out with a period of three months, from July to September, 2023. Approval of Ethical clearance was obtained from the Institutional Ethical Committee (IEC) NHREC No. RSUTH/REC/2023326, dated: the 24th July, 2023.
Specimens’ collection
Specimen collection in this study was done following strict aseptic precautions from clinically suspected cases of candidiasis. Three types of clinical Specimens- High vaginal swabs (HVS), Urine, and Oral Swabs (OSs) were collected in this study using sterile swabs and bottles for appropriate specimens. The specimens were collected from inpatients and outpatients from the Departments of Gynecology, Pediatrics and Intensive Care unit (ICU), as well as Department of Medicine and Surgery of RSUTH. Comprehensive clinical history of all patients in this study was recorded but only age and sex were considered as demographic data in this study.
The following guidelines as described by 14 for the collection of clinical specimens were duly followed during the study.
1. Sterile collection devise and containers were used to collect the specimens
2. Specimens were collected under strict aseptic precautions
3. Sufficient specimens were collected
4. Specimens were collected from an active lesion containing viable organisms
5. The specimens were labeled appropriately
The methods employed in collecting these specimens from various sources were as follows:
1. High vaginal Swabs (HVSs): As speculum examination was done and the vaginal discharge was collected with the aid of sterile swabs from the posterior fornix.
2. Urine sample: Fresh mid-stream and clean catch urine of about 20-50ml was collected in sterile screw-capped containers.
3. Oral (Mouth) Swabs: With the aid of a tongue depressor, the lesions were visualized and the specimens were collected using a sterile swab. All specimens were transported immediately to the laboratory for analysis.
Sample size
A total of 206 clinical samples with suspected cases within the period of July to September, 2023 made up the sample size for this investigation.
Inclusion criteria
Patients (male and female) of all age group were included in the study. All specimen showing Candida isolation from samples were also included in the study
Exclusion Criteria
Patients who were on antifungal treatment were excluded from the study
Culturing of Candida species from clinical sample
Candida species in this study were cultured using the streak method. All the clinical samples of HVS and oral swabs were streaked on the sterile surface of Saboraud Dextrose Agar (SDA) (Titen Biotech Ltd India) amended with Tetracycline. For the urine samples, a sterile swab stick was dipped into the urine before it was streaked onto the surface of the sterile SDA. They were labeled accordingly and incubated at room temperature for 2 – 5 days and examined daily for growth 15, 14. Following incubation, colonial examinations of each isolate with respect to the clinical sample were identified for colour, shape, size and texture 16.
Isolation, Purification and Preservation of Isolates
Yeast cultures were isolated by streaking using a sterile wire loop on freshly prepared SDA and incubated for 3 days at room temperature so as to obtain pure isolates. Following incubation, the discrete single colony of each isolate that were grown along the line of streak was further grown on SDA using a sterile cotton wool. The pure isolate was then preserved in 15% sterile glycerol solution for further use.
Identification and Characterization of colonies
The colonies of yeast isolates were identified by the colony characters (cultural characteristics) as describe by 16, Gram staining and sugar fermentation.
Gram stain
Smears of each colony were made on a clean grease free slide, then heat fixed after air drying by passing the reverse side of the slide over a flame of Bunsen burner. The smears were stained by Gram’s method using crystal violet (60 sec) Lugol’s iodine (60 seconds), and decolorized with 95% alcohol till no colour appeared to ooze out, then counterstained for 40 seconds using Safranin, while washing was done after each stain was used. The smears were blot dried and observed under oil immersion for shapes and cream reactions 17.
Sugar Fermentation
Three carbohydrate broths were used in this study for the sugar fermentation test, each containing 1% glucose, Lactose and sucrose separately with 1% peptone and 0.005% phenol red indicator. Inverted Durham’s tubes were immersed for gas detection. All the broths were sterilized by autoclaving at 121oC for 15 minutes. On cooling the yeast colonies were inoculated into each, broth and incubated at 25oC for 2-3 days and examined at 24 hour intervals for acid (yellow colouration) and gas (space in Durham tubes) production.
Preparation of antifungal Agents
The antifungal agents used were 200mg Fluconazole capsule BP (Mancare Pharmaceuticals PVT LTD, India), 200mg Ketoral (Ketoconazole) Tablet USP (Laborate Pharmaceuticals LTD, India) Microzol-Plus containing 200mg Micronazole Nitrate and 750mg Metronidazole Tablet (Drugfield Pharmaceuticals LTD, Nigeria); 500000IU Nystatin Tablet (Mekophar Chemical Pharmaceutical Joint- Stock Company, Vietnam) and 250mg Itracap (Itraconozole)(Genix Pharma PVT, LTD, Pakistan). A twofold dilution of each stock solution of antifungal agent was prepared by diluting from the stock to the least concentration. Concentrations of 100µg/ml, 50µg/ml, 25µg/ml, 12.5µg/ml, 6.25µg/ml, 3.124µg/ml and 1.56µg/ml were prepared and were used to impregnate the sterile perforated WhatmanNo. 1 filter paper discs
Preparation of Fungal Suspension for Agar Diffusion Test
The inoculums of yeast isolates were grown in Tryptic Soy broth (TSB) medium for 18-24hrs, and the turbidity of the medium was adjusted by adding sterile normal saline until the turbidity matches that of 0.5 McFarland standard 18.
Inoculation of Agar Plates for Agar Diffusion Test
With a sterile swab was dipped into the already prepared inoculums and rotated firmly against the upper inside wall of the test tube for many times in order to remove excess fluid, the test yeast isolates were inoculated onto the dried sterile surface of SDA amended with tetracycline by streaking until the entire surface was covered. The plates were left for about 5 minutes in order for the surface moisture to be absorbed before applying the drug impregnated discs.
Antifungal Susceptibility Testing
In compliance with Clinical and Laboratory Standards Institute 19 guidelines the agar disc diffusion techniques were employed in the antifungal susceptibility testing. The drug impregnated discs were taken out form the containers using a pair of sterile forceps, and they were then placed onto of the yeast infected Saboraud Dextrose Agar. The discs were tightly pressed down to make contact with the SDA’s surface using the sterile forceps. All plates were incubated at 370C for 48-72hrs 14.
Reading of the Plates and Measurement of Diameter of Zone of Inhibitions
After the incubation period, the plates were evaluated. Using a meter rule, the diameter of the zone of complete inhibition was measured and the Mean values were recorded in millimeters, rounding to the nearest whole number. The susceptibility (sensitivity), Intermediate or Susceptible-Dose Dependent (S-DD), and Resistance to the antifungal drugs to the test isolates were measured and compared to the standard zone interpretive breakpoints provided by the CLSI M44-A2 recommendations 14; 15.
Statistical Analysis
Patients’ information was collected through oral questionnaires. The risk factors of infection type and the data obtained in this study were in this study were statistically analyzed using IBM SPSS statistic for windows version 26/IBM Corp Armonk. NY. USA. Descriptive statistics such as Mean, Standard Deviation (SD), Tables and Proportional Annova were used to describe the data. Difference between propositions was analyzed using X2 tests, if the sample sizes were small or unbalanced. A two tailed p-value< 0.05 was considered statistically significant Table 1.
Table 1. Interpretive categories: breakpoint zone diameter (mm) for Candida species| Antifungal Agents | Disc Content (µg) | Sensitive (S) | Susceptible-Dose Dependent (S-DD) | Resistant (R) |
| Fluconazole | 25 | >19mm | 15 – 18mm | < 14mm |
| Ketoconazole | 10 | >20mm | 10 – 19mm | <9mm |
| Miconazole | 10 | >20mm | 17 – 19mm | < 16mm |
| Nystatin | 50 | >15mm | 10 – 14mm | < 9mm |
| Itraconazole | 10 | >17mm | 14 – 16mm | < 13mm |
Results
An uneven distribution of patient ages was seen in this study as shown in Table 2, with a large number of patients (82.0%) falling into the 11-40 years age group, with a mean age of 1.86+ 0.344. The range of ages among the patients was 4 months old to 73 years. The age range of 11 to 30 has the greatest frequency.
Table 2. The Patients Age Distribution| Gender | |||
| Age | Female | Male | Total |
| 0.10 | 7 | 2 | 9 |
| 11-20 | 51 | 5 | 56 |
| 21-30 | 63 | 3 | 66 |
| 31-40 | 43 | 6 | 49 |
| 41-50 | 8 | 9 | 17 |
| 51 and above | 6 | 3 | 9 |
| Total | 178 | 28 | 206 |
The distribution of patients in this investigation based on gender is presented in Table 3. The results showed a higher percentage (86.4%) for female patients as compared to the male patients (13.6%) and this implies that the females outnumbered the males in this study. At p = 0.000, the patients’ gender distribution showed a statistically significant difference of 36.59, p<0.01.
Table 3. Patients Distribution based on Gender| Gender | No of patients | Percentage |
|---|---|---|
| Female | 178 | 86.4 |
| Male | 28 | 13.6 |
| Total | 206 | 100 |
The total of 44 samples out of the 206 specimens collected, tested positive in this study for Candida species giving a prevalence of 66.1% (p<0.513), as shown in Table 4. Out of these 44 positive cases from the various specimens, 25(23.8%) were positive for HVS, 14(17.3%) from urine and 5(25.0%) from oral swabs. There was no statistically significance difference at p<0.513 among the specimens.
Table 4. Distribution of Culture Positive Cases according to Clinical specimen| Clinical Samples | No. of Sample Screened | Total number of isolates | Percentage |
|---|---|---|---|
| HVS | 105 | 25 | 23.8 |
| Urine | 81 | 14 | 17.3 |
| Oral swabs | 20 | 5 | 25.0 |
| Total | 206 | 44 | 66.1 |
The results of the culture positive cases of Candida species according to age and gender in this study is shown in Table 5. Out of the 44 isolates obtained from various clinical specimens, 20 (48.7%) were isolated from the female patients within the age group of 31-40 years and this was the highest prevalence of Candida species observed in this study. Following that, 14 (34.1%) positive cases were isolated from female patients in the age group of 21-30 years while 5 (12.2%) were isolated from those of the age 11-20 years of age as the least 1 (2.4%) were found within the age group of 41 years and above for the females. For the male patients, 1 (33.3%) positive case was observed for those within the age group of 0-10 years, 11-20 years and 41-50 years. The prevalence percentage of positive cases in this investigation showed that females (93.2%) were greater than males (6.8%) with statically significant difference of 25.112 at p=0.000 Figure 1.
Table 5. Culture positive cases according to Age and Gender| Age Groups | Female (%) | Male (%) | Total |
|---|---|---|---|
| 0-10 | 0 | 1 (33.3%) | 1 |
| 11-20 | 5 (12.2%) | 1 (33.3%) | 6 |
| 21-30 | 14 (34.1%) | 0 | 14 |
| 31-40 | 20 (48.7%) | 0 | 20 |
| 41-50 | 1 (2.4%) | 1 (33.3%) | 2 |
| 51 and above | 1 (2.4%) | 0 | 1 |
| Total | 41 (93.2%) | 3 (6.8%) | 44 |
Figure 1.Plates showing Culture Positive Cases
The prevalence of Candida species according to Clinical samples as shown in Table 6 showed a total of 44 isolates with 25 (56.8%) from HVS, 14 (31.8%) from urine and 5 (11.4%) from oral swabs. Candida albicans in this study was the most prevalent species accounting 22 (50%) whereas the non-albicans Candida (NAC) made up the other 50% of the total isolates. The prevalence rate of Candida albicans were 13 (59.1%), 7 (31.8%) and 2 (9.1%) for HVS, urine and oral swabs respectively, C. glabrata was 2 (50%), 1 (25%) and 1 (25%), C. kruseiwas 4 (50%), 3 (37.5%) and 1 (12.5%); C. parapsilosis4 (80%) and 1 (20%) from HVS and urine respectively; C. pelliculosa 1 (100%) from HVS only whereas C. tropicalis was 1 (25%), 2 (50%) and 1 (25%) from HVS, urine and oral swabs, respectively Figure 2.
Table 6. Prevalence of Candida species according to Clinical Samples| Candida species | Specimens Hvs | Urine | Os | Total number of isolate | Percentage (%) |
| C. albicans | 13(50%) | 7(31.8%) | 2(9.1%) | 22 | 50 |
| C. glabrata | 2(50%) | 1(25%) | 1(25%) | 4 | 91 |
| C. krusei | 4(50%) | 3(37.5%) | 1(12.5%) | 8 | 18.2 |
| C. parapsilosis | 4(80%) | 1(20%) | 0 | 5 | 11.4 |
| C. pelliculosa | 1(100%) | 0 | 0 | 1 | 2.2 |
| C. tropicalis | 1(25%) | 2(50%) | 1(25%) | 4 | 9.1 |
| Total | 25(36.8%) | 14(31.8%) | 5(11.4%) | 44 | 100 |
|---|
Figure 2.Plates showing zone of inhibitions of Antifungal agents to Test Isolates.
The results of the Antifungal Susceptibility Pattern of Candida species in this study is presented in Table 7. In the present investigation, out of the 44 Candida isolates tested, Itraconazole demonstrated resistance in 34.1% cases studied. This was observed to be the most resistant among the antifungal agents. Miconazole and Nystatin showed resistance of 18.2%. The susceptible –Dose dependent was high in Itraconazole (36.4%), followed by Nystatin (29.3%) and Miconazole (22.7%). The highest sensitivity was noted in this study for Fluconazole (79.5%) and Ketoconazole (77.3%), 18.2% showed resistance and 2.3% and 4.5% showed Susceptible-Dose Dependent to Fluconazole and Ketoconazole respectively. Among the Candida species examined, C. albicans was most sensitive to all the antifungal agents followed by C. krusei, C. glabrata and C. parapsilo
Table 7. Antifungal Susceptibility Pattern of Candida species| Candida Species | Fluconazole | Ketoconazole | Miconazole | Nystatin | Itraconazole | |||||||||||||
|---|---|---|---|---|---|---|---|---|---|---|---|---|---|---|---|---|---|---|
| S | SDD | R | S | SDD | R | S | SDD | R | S | SDD | R | S | SDD | R | ||||
| C. albicans | 19 (86.4%) | 0 | 3 (13.6) | 18 (81.9%) | 1 (4.5%) | 3 (13.6%) | 15 (68.2%) | 4 (18.2%) | 3 (13.6%) | 13 (59.1%) | 6 (27.3%) | 3 (13.6%) | 11 (50%) | 6 (27.3%) | 5 (22.7%) | |||
| C. glabrata | 3 (75%) | 0 | 1 (25%) | 3 (75%) | 0 | 1 (25%) | 2 (50%) | 1 (25%) | 1 (25%) | 2 (50%) | 1 (25%) | 1 (25%) | 0 | 3 (75%) | 1 (25%) | |||
| C. krusei | 7 (87.5%) | 0 | 1 (12.5) | 6 (75%) | 1 (12.5%) | 1 (12.5%) | 5 (62.5%) | 2 (25%) | 1 (12.5%) | 3 (37.5%) | 4 (50%) | 1 (12.5%) | 1 (12.5%) | 4 (50%) | 3 (37.5%) | |||
| C. parapsilosis | 4 (80%) | 0 | 1 (20%) | 4 (80%) | 0 | 1 (20%) | 2 (40%) | 2 (40%) | 1 (20%) | 3 (60%) | 1 (20%) | 1 (20%) | 1 (20%) | 2 (40%) | 2 (40%) | |||
| C. pelliculosa | 0 | 0 | 1 (100%) | 0 | 0 | 1 (100%) | 0 | 0 | 1 (100%) | 0 | 0 | 1 (100%) | 0 | 0 | 1 (100%) | |||
| C. tropicalis | 2 (50%) | 1 (25%) | 1 (25%) | 3 (75%) | 0 | 1 (25%) | 2 (50%) | 1 (25%) | 1 (25%) | 2 (50%) | 1 (25%) | 1 (25%) | 0 | 1 (25%) | 3 (75%) | |||
| Total | 35 (79.5%) | 1 (2.3%) | 8 (18.2%) | 34 (77.3%) | 2 (4.5%) | 8 (18.2%) | 26 (59.1%) | 10 (22.7%) | 8 (18.2%) | 23 (52.3%) | 13 (29.5%) | 8 (18.2%) | 13 (29.5%) | 16 (36.3%) | 15 (34.1%) | |||
Discussion
Distribution of patients according to Age
The current investigation revealed that among the patients who visited Rivers State University Teaching Hospital, Port Harcourt, both sexes and all ages can develop candidiasis as the study identified the particular types of Candida that results infections. The oldest participant in our study was 73 years old, and the youngest was a four-month – old baby giving a mean age of MeanAge 1.86+ 0.344 years. The age range of 11-40 years old accounted for bulk of the patients in this study, which may be explained by the fact that this is the age group with the highest rates of pregnancy, sexual activity and hormonal volatility. This results is however, lower when compared to the study of 20 who in their study reported the mean age group of 43.4 years. The result of this study is consistent with other studies as many investigations noted high rate in the age group of 20-49 years 14; 21. Patients’ age has a major influence on how susceptible they are to candidiasis especially if they are older than 65 years. Candida infections are more likely to cause death in the elderly especially in those over 65 years. Individuals in the reproductive age group are particularly susceptible to immune system and hormone variations. The distribution of Candida infections is influenced by these variables as well as physiological changes associated with ageing 22
Distribution of patients according to gender
The study revealed that female patients 178 (86.4%) were higher when compared to male patients 28 (13.6%), which indicated that the females surpassed in number the males. This high distribution of females as noticed in this study has proven that they are mostly infected than the males. This finding is in conformity with the report of 14. Similarly, the study also agrees with the report of 23, and 24, who had stated high distribution of females than males in the study but disagrees with the study of 25, who stated that males are commonly infected than females with an incidence of 94 (62.6%) and 56 (37.3%), respectively. Gender has a major role in the clinical research of candidiasis in different age groups, male and female exhibit different infection rates and yeast growth intensities 26. This emphasizes how gender differences in the epidemiology and clinical symptoms of candidiasis must be taken into account.
Distribution of Candida species according to clinical samples.
The prevalence of Candida species with respect to the clinical specimens showed high distribution of 66.1%. The prevalence rate observed in this study is said to be higher compared to those reported by 27, who reported 26%. 28 and 29 had reported the prevalence rate of 30.7% and 30% in Jamaica and Nigeria respectively. This finding is however higher than the above results. The prevalence of Candida isolates in this study fluctuates with respect to the clinical specimens, and these results is in agreement with the report of 24, who documented in Ghana that high prevalence of Candida infection was isolated from HVS compared to urine. The high frequency of HVS and Oral Swabs observed in this research could be attributed to the vaginal and oral environment which could be influenced by hormonal changes, pH level, and the presence of glycogen.
Distribution of Culture Positive Cases according to Age and Gender
Age and sex are two main factors influencing candidiasis, with older people more prone to infections and invasive candidiasis is more common in women. These pre-disposition are further influenced by variation in the strength of yeast growth in males and females 30. Comprehending these variables is imperative for proficient handling and avoidance of candidiasis. In our study, the prevalence of positive cases of Candida species with respect to gender and their age showed an inequitable distribution. The high prevalent of Candida species among the age group of 21-40years conforms with the study earlier reported by 25, that the majority of patients were in the age group of 21-60 years. 31, had similarly reported high incidence of Candida species in women in the age range of 17-44 years, while 14, reported high incidence of Candida species in the age group of 20-49 years.
Our investigation revealed that both sexes and all ages can get candidiasis. High infection rate in the age group as observed in this study for the females may be probably due to the indiscriminate drug usage, especially contraceptives among females; decreases levels of protection cervical antibodies in the reproductive tract, practice poor hygiene, history of antibiotics or drug misuse, hormonal factors, anatomical differences and diabetes.
In the research we conducted, substantial gender disparities were seen when the number of yeast colonies in the entire group were analyzed with respect to age. The number of yeast colonies in female group varies with age and this agrees with the study of 30. Rural women had an elevated rate of infections owing mostly to conditions of poor medical care, lack of health education, scarce economic resources and difficulty in timely medical treatment as documented by 32 and this also may contribute to the high prevalence of Candida species in this study.
Distribution of Candida species according to clinical samples
In our study we identified 44 species of Candida, with Candida albicans 22 (50%) being the most prevalent. Among the non-albicans Candida species it was observed in this study that C. krusei 8 (18.2%) demonstrated increased prevalence proceeded by C. parapsilosis 5 (11.4%), C. glabrataand C. tropicalis 4 (9.1%), respectively and the least was C. pelliculosa1 (2.2%) which aligns with the publicly available reports from various global location 14; 1; 16. 15; and 33. The high prevalence of Candida species from HVS in this study is concordant with the study of 34. Candida species has been stated to be the fifth most frequent nosocomial infections in hospitals with C. albicans accounting for 76-89% in VVC and 25% in Urine, followed by non-albicans Candida and fourth most frequently isolated pathogens from blood stream [35; 25; 4. and 14). C. albicans being the most prevailing Candida species in this study has been reported for several decades to be the primary cause of invasive infections that can be fatal. Globally, it is the most frequent cause of mucosal and systemic infections that accounts for over 70% fungal infection. C. albicans is the primary cause of candidemia 36.
Antifungal Susceptibility Pattern of Candida species
The in vitro susceptibility of Candida species recovered from different clinical samples was determined in this study. Fluconazole, Ketoconazole, Miconazole, Nystatin and Itraconazole are the antifungal medications that were examined. Based on their widespread availability in the local market and their status as hospital prescription medications, the antifungal agents utilized in this investigation were selected. The results of our study indicated that 34.1% of all the Candida species were resistant to Itraconazole, whereas 18.2% were resistant to Fluconazole, Ketoconazole, Miconazole and Nystatin respectively. This is in conformity with the result of 25, and 15. Among the species that infect humans most frequently is Candida albicans. The non-albicans Candida in this study corresponds with Candida albicans and their identification is vital since non-albicans Candida are more resistant to azoles than C.albicans. Despite their similarities, Candida albicans and non-albicans Candida (NAC) species differ in terms of their virulence traits, susceptibility to antifungal agents and incidence studies 14.
All the isolates of Candida species in this study displayed susceptibility to Fluconazole, Ketoconazole, Miconazole and Nystatin at varying degrees except C. pelliculosa which showed 100% resistant to all agents. The percentage susceptibility of antifungal agents to the isolates showed 79.5% for Fluconazole, 77.3% for Ketoconazole which were the highest susceptible antifungal agents. Following this agent were Miconazole (59.1%) and Nystatin (52.3%) and this agrees with the document of 14 and 31 but was in contrast to the findings of 4, 15. In this study, Candida albicans showed 86.4% and 81.2% to Fluconazole and Ketoconazole respectively and this agreed with the report of 31, 37, but in contrast to the study of 38 and 25 .Candida albicans in this study showed 22.7% resistance to Itraconazole and this conform with the study of 14.
Increase in the resistance to fluconazole had been documented to rise from 2.4% to 55.4% within 2006- 2012, but the rate dropped to 8.9% in 2013. In the same vein, there has been considerable increase in the resistance of Miconazole and Itraconazole from 2.4% and 7.1% respectively, from 2006-2023 39. Despite the similarities in the disease spectrums between Candida species, their susceptibilities to agents and degrees of severity vary, which helps to explain their epidemiology and manner of transmission 40.
Many potential reasons have been attributed to the high resistance rates observed in some Candida species in this study. Amongst these reasons are:
Adaptability of Genes: As documented by 41, one of the major reasons for high resistance rates in some Candida species is the adaptability of their genes. The genetic adaptability of Candida yeasts enables them to swiftly adapt to new surroundings due to their great chromosomal fluidity. By causing genetic modifications, this adaption may cause resistance populations to arise.
Secondly, antifungal use is another potential reason for high resistance rates observed in some Candida speciesin this study and this agrees with the study of 42. The accumulation of resistance in some Candida species has been facilitated by the overuse and neglect of antifungal medications, such as azoles. This happens as a result of the medications’ ongoing exposure, which favours mutant alleles that provides higher resistance.
Again, heterogeneity loss is another reason observed in this study that is responsible for high resistance rates observed in some Candida species. This has also been reported by 41. Alleles with point mutations in diploid fungi that have undergone genetic variability can become homozygotes. This may results in resistance building and infectious persistence.
The production of biofilm as seen in many of the Candida species in this study also contributed to their high resistance rates. Candida yeasts have the ability to produce biofilms, which let them to thrive when contacted by antifungal medications. This conforms to the study of 43. The development of resistance may be triggered by the capacity of Candida to build biofilms.
Furthermore, the techniques of Charles Darwin’s theory termed “Evolutionary Mechanism” in some Candida species also promote high resistance rates in some yeast in this study. Unlike bacteria, where resistance is frequently results from the transmission of DNA migratory components, the resistance in Candida often emerges through genetic changes within an evolutionary branch. This is in agreement with the study of 44, in their study of Evolutionary Emergence of Drug Resistance in Candida Opportunistic Pathogens
Moreso, variations in physiology has been reported by 44, as another key reason for the high resistance rates in some Candida species as seen in this study. When compared to other species of Candida, several species show clear variations in glycerolipids, sphingolipids, cell wall content, and sterol composition. The innate resistance in these Candida species isolated in this study may be influenced by these distinctions.
Species-Unique susceptibility also contributes to the high resistance in some of the studied Candida species and this agrees with the study of 44. When it come to antifungal medications, Candidapelliculosa, for example, shows different susceptibility profiles than other Candida species. This implies that various species may employ various strategies to avoid being resistant to antifungal drugs.
Demographic variables are other contributory factors of high resistance rates of some Candida species in this study and this agrees with the report of 45. The durability and dissimilation of resistance isolates may be influenced by the region of distribution, severity and circulation characteristics of the isolates.
Conclusion
The isolation of Candida species in this study indicated that non-albicans Candida species (NAC) corresponds with Candida albicans and that candidiasis could be associated with both gender at all ages. The study revealed that C. albicans was the most prevalent isolate. The current investigation concluded by demonstrating that non-albicans Candida (NAC) species were more common in a variety of clinical specimens, while Candida albicans were the most prevalence across all specimens. The infection of Candida is rising globally as a result of a rise in the predisposing circumstances. Some non-albicans species of Candida have an innate resistance to Itraconazole while most sensitivity of Candida species was noted with Fluconazole and Ketoconazole. Therefore, early classification of Candida isolates in hospital settings and their antifungal susceptibility testing will limit the direct application use of antifungal medications and have a significant impact on physician’s treatment options, which will benefit patients. This study highlights the importance of routinely monitoring the antifungal susceptibility pattern of common Candida species, as this will help patients utilize antifungal medications wisely and prevent the establishment of new infections.
Acknowledgments
The authors would like to thank the Rivers State University Teaching Hospital, Port Harcourt, The Department of Science Laboratory Technology, School of Applied Sciences, Kenule Beeson Saro-Wiwa Polytechnic Bori and the CHIMDI ODU FOUNDATION.
References
- 1.Pawar M, R N Misra, N R Gandham, Angadi K, Jadhaw S. (2015) . Prevalence and Antifungal Susceptibility Profile of Candidaspecies Isolated from Tertiary Care Hospital, India. Journal of Pharmaceutical and Biomedical Sciences 5(10), 812-816.
- 2.J P Lopes, M S Lionakis. (2022) Pathogenesis and Virulence of Candida albicansVirulence. 13, 89-121.
- 3.Dadar M, Tiwari R, Karthik K, Charkrobory S, Shahali Y et al. (2018) Molecular Characterization, Pathogenicity, and Advances in Diagnosis and Control- An Update. Microbial Pathogenesis. 1, 128-138.
- 4.Sathi F A Paul, S K Aued, Alam S, M, A S. (2022) Prevalence and Antifungal Susceptibility of Clinically Relevant Candida Species, Identification of Candida auris and Kodamneaohmeri in Bangladesh. Trop Med Infect.Dis. 7(9), 211.
- 6.Patel M, D F Kunz, V M Trivedi, M G Jones, S A Moser. (2005) Initial management of Candidemia at an academic medical center: evaluation of the IDSA guidelines.Diagnostic Microbiology and Infectious Disease. 52(1), 29-34.
- 7.S C Deorukhkar, Saini S, Mathew S. (2014) Non-AlbicansCandidaInfection: An Emerging Threat.Interdisciplinary Perspectives on Infectious Diseases. 615958.
- 8.X L Tang, Hua Y, Guan Q, C H Yuan. (2016) Improved detection of deeply invasive candidiasis with DNA aptamers specific binding to (1!3)-b-D-glucans from Candida albicans. , Eur. J. Clin. Microbiol. Infect. Dis,35 587-595.
- 9.Safdar N, J W Baddley, Alexander B, Brumble L, Freifeld A. (2016) The Epidemiology and outcomes of invasiveCandida infections among organ transplant recipients in the United States: results of the Transplant-Associated Infection Surveillance Network (TRANSNET). 10-4103.
- 10.Horn D L Neofytons, Anaissie D, E J Fishman, J A Stienbach, J W. (2009) Epidemiology and outcomes of candidaemia in 2019 patients: data from the prospective antifungal therapy alliance registry. , Clin. Infect. Dis 48, 1695-1703.
- 11.Krcmery V, A J Barnes. (2002) Non albicnasCandidaSpp. Causing Fungaemia:Pathogenicity and Antifungal Resistance Journal of Hospital Infection. 50(4), 343-360.
- 12.Sav H, Altibas R, Z B Dursun. (2020) . Fungal Profile and Antifungal Susceptibility Pattern in Patients with Oral Candidiasis. Le Infezion in Medicina 3, 392-396.
- 13.Weiderhold N. (2021) Antifungal susceptibility testing: A prime for clinicians. Open forum infectious diseases. 8(11), 93-100.
- 14.Amar C S Ashish, Hajare J, Sreekantha V, Yogesh S, B. (2013) . Study of Prevalence and Antifungal Susceptibility of Candida.InternationalJournal of Pharma and Bio Sciences 4(2), 361-381.
- 15.Chongtham U, D C Athokpam, R M Singh. (2022) Isolation, identification and Antifungal Susceptibility Testing ofCandidaspecies: A cross-sectional study from manipur. India.Journal of Clinical and Diagnostic Research 6(4).
- 16.Ajah H A Hassan, S A, G K Rahi. (2020) Isolation and Identification ofCandidaspecies from Oral and Vaginal and Determination of Virulence Factor. Plant Archives. 20(1), 2697-2706.
- 18.J M Andrews. (2001) Determination of Minimal Inhibitory Concentration.Journalof Antimicrobial Chemotherapy. 48, 5-16.
- 19.Clinical. (2008) Laboratory Standards Institute. Method for Antifungal Disk Diffusion Susceptibility Testing of Yeats. Approved Standard M44-A2.
- 20.Sahni V, Agarwal S K Singh, Anuradhy S N P, Sikdar. (2005) S.,et al.Candidamia under-recognized nosocomial infection. in India hospitals.J. Assoc. Physicians India 53-67.
- 21.Nelson M, Wanjiru W, M W. (2013) Prevalence of Vaginal Candidiasis and Determination of the Occurrence ofCandidaSpecies in Pregnant Women Attending the Atenatal Clinic of Thika District Hospital. , Kenya.Open Journal of Medical Microbiology 264-272.
- 22.Fink M, Klein K, Sayers K, Valentina J, Lemonardc C. (2020) Objective Data Reveals Gender Preferences for Patients Primary Care Physician.Journal of Primary care and Community Health. 2-50132720964.
- 23.Muzaheed Alshehri, B A Raboan, A, O S El-Masry, Acharya S. (2002) . A 20 – year retrospective Clinical Analysis ofCandidainfections in Tertiary Center. Single – Center Experience.Journal of Infection and Public Health 15.
- 24.K, H A Bentil, Gyesi E, Amoah S, Entasi B. (2003) Candidiasis Profile at the outpatient department of the Univeity of Cape Coast hospital in the Central Region of Ghana a retrospective study.BMC Women’s Health. 23, 101.
- 25.N Penmetcha Shaik, Myneni U, R B Yarlagadda, P, Singamsetty S. (2016) A study of identification and Antifungal Susceptibility pattern ofCandidaspecies isolated from various clinical specimens in a Tertiary Care Teaching Hospital Chinakakani, Cuntur, Andhra Predesh, South India.International Journal of Current Microbiology and Applied Sciences. 3(7), 71-91.
- 26.Choi J E Jeon J S, J K Kim. (2023) Distribution Analysis of Candida albicans according to sex and Age in Clinical specimens testing for sexually Transmitted Diseases.J. , Microbial Biotechnic 33(1), 123-126.
- 27.A, G O Babalola, M O Shittu, M A Tijani, S A Adekola. (2015) Detection and Epidemiology of Vulvovaginal Candidiasis among Asymptomatic Pregnant Women Attending a Tertiary Hospital in Ogbomoso, Nigeria.Int. J Biomed Res. 6(7), 518-523.
- 28.Kamara P, Hylton-Kong T, Brathwaite M. (2000) Vaginal Infections in Pregnant women in Jamaica: Prevalence and Risk Factors.Int. , J Std 11(8), 516-520.
- 29.Okonkwo N, Umeanaeto P. (2010) Prevalence of Vaginal Candidiasis among Pregnant Women in. , Nnewi Town of Anambra State, Nigeria.Afr. Res. Rev 4(4), 539-548.
- 30.Loster J E Weiczoreck A, B W Loster. (2016) Correlation between Age and Gender inCandidaspecies Infections of complete Denture Wearers, a retrospective analysis.Clinical interventions in Aging. 1707-17.
- 31.Khan M, Ahmed J, Gul A, Ikram A, Lalani M. (2018) Antifungal Susceptibility Testing of VulvovaginalCandidaspecies among Women attending Antenatal Clinic in Tertiary Care Hospital of Peshawar.Journal of Infection and Drug Resistance. 11, 447-456.
- 32.Mulu W, Yimer M, Zenebe Y, Abera B. (2015) Common causes of Vaginal Infections and Antibiotic susceptibility of Aerobic Bacterial isolate in woman of reproductive age attending at Felegehiwot referral hospital, Ethiopia; a cross sectionals Study.BMC Women’s Health. 15(1), 42.
- 33.Cernakova L, Liskova A, Lengyalova L, C F Rodriguas. (2022) Prevalence and Antifungal Susceptibility Profile of Oral Candida spp. Isolated from Hospital in Slovakia.Medicina. 58, 576.
- 34.Oyewole O, Okoliegbe I, Alkhalil S, Isah P. Federal University of Technology (2013) Prevalence of Vaginal Candidiasis among Pregnant women attending. , Minna, Nigeria, Bosso 4(1), 113-120.
- 35.Carsello S, Spinillo A, Osnango G. (2003) An Epidemiological survey of Vulvovaginal Candidiasis in Italy.Eur. 110(1), 55-72.
- 36.Talapko J, Juzbsio M, Matijevic T, Pustijanac E, Bekic S. (2021) . Candida albicans – The virulence Factors and Clinical Manifestations of infection.J. Fungi (Basel),1(2): 79.
- 37.Mondal S, Mondal A, Pals N, Banerjee P, Kumar S. (2013) . Species Distribution and in vitro Antifungal Susceptibility, Patterns ofCandida.Journal of Institute of Medicine Nepal 35(1), 45-49.
- 38.L G Jayalakshmi, S H Ratmakumari, Samson. (2014) Isolation, speciation and Antifungal Susceptibility Testing ofCandidafrom Clinical specimens at a Tertiary Care Hospital.Blood,13(06).
- 39.Wang B, L H Huang, Zhao J-X, H Wang Fang, D-Y. (2015) ERG11 Mutations Associated with Azole Resistance inCandidaalbicansisolates from Vulvornginal Candidasis Patients. Asian Pac.J. Trop Biomed,5. 909-914.
- 40.M A Pfaller, D R Andes, D J, D L Horn, Reboli A et al. (2014) Epidemiology and Outcomes of Invasive Candidiasis due to non-albicans species ofCandidain 2,149 Patients: data from Prospective Antifungal Therapy (PATH) Registry. 9(7), 101510.
- 41.S E Murphy, Bicanic T. (2021) Drug Resistance and Novel Therapeutic Approach. in Invasive Candidiasis.Front. Cell. Infect.Microbiol,11: 759408.
- 42.Garcia-Effron G. (2023) The Rising Threat of Intrinsically ResistantCandidaspecies. in Argentina.RevistaArgentina deMicrobilogia 55(3), 201-203.
- 43.Costa-de-Oliviveira S, A G Rodrigues. (2020) albicansAntifungal Resistance and Tolerance in Bloodstream Infections: The Triad Yeast-Host-Antifungal.Microorganisms,8(2):. 154.
